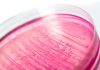
First CRISPR-armed phage therapeutic can specifically target and remove E. coli in the human gut

Some genetic disorders-such as cystic fibrosis, hemophilia and Tay Sachs disease-involve many mutations in a person’s genome, often with enough variation that even two individuals who share the same disorder might have a different combination of mutations. Complexities like these make it challenging to develop broadly applicable gene therapies for these disorders.
Researchers at The University of Texas at Austin now have developed an improved method of gene editing that is precise, more efficient than other similar methods and can correct many disease-causing mutations at once in mammalian cells. They also demonstrated its effectiveness in correcting scoliosis-causing mutations in zebrafish embryos. The new method uses genetic elements from bacteria called retrons that help protect the microbes from viral infection. This is the first time researchers have corrected a disease-causing mutation in vertebrates using retrons, raising hopes of new gene therapies for human disorders.
“A lot of the existing gene-editing methods are restricted to one or two mutations, which leaves a lot of people behind,” said Jesse Buffington, a graduate student at UT and co-author of a new paper in Nature Biotechnology. “My hope, and what drives me, is to develop a gene-editing technology that’s much more inclusive of people who might have more unique disease-causing mutations, and that using retrons will be able to expand that impact onto a much broader patient population.”
Buffington co-led the research, which was supported in part by Retronix Bio and the Welch Foundation, with Ilya Finkelstein, a professor of molecular biosciences at UT.
Because the new method can replace a large stretch of defective DNA with a healthy sequence, the same retron-based package can fix any combination of mutations within that stretch of DNA without having to be specific to any one person’s genetics.
We want to democratize gene therapy by creating off-the-shelf tools that can cure a large group of patients in one shot. That should make it more financially viable to develop and much simpler from a regulatory standpoint because you only need one FDA approval.”
Ilya Finkelstein, professor of molecular biosciences, UT
Other researchers have used retrons for gene editing in mammalian cells, but these methods were highly inefficient. The best version could only insert new DNA into the genomes of about 1.5% of the cells it targeted. The method developed at UT inserts the new DNA into about 30% of the targeted cells, and the researchers see potential for improving this editing efficiency even further.
Another benefit of the new method is that it can be introduced into cells as RNA encased in a lipid nanoparticle. The nanoparticles are engineered to mitigate problems with other traditional gene-editor delivery methods.
The UT team is currently applying their approach to develop gene therapies for cystic fibrosis (CF), a disease caused by mutations in the CFTR gene that leads to thickened mucus in the lungs, causing chronic infections and progressive lung damage. The team recently received a grant to support this work from Emily’s Entourage, a non-profit focused on finding a cure for the 10% of individuals in the CF population who do not benefit from currently available mutation-targeted therapies. They are beginning work on replacing defective portions of the CFTR gene in cells that mimic CF pathology and eventually in airway cells derived from CF patients.
“Traditional gene-editing technologies work best with single mutations and are expensive to optimize, so gene therapies tend to focus on the mutations that are the most common,” Buffington said. “But there are over a thousand mutations that can cause CF. It’s not financially feasible for companies to develop a gene therapy for, say three people. With our retron-based approach, we can snip out a whole defective region and replace it with a healthy one, which can impact a much larger part of the CF population.”
A separate grant from the Cystic Fibrosis Foundation will fund similar work on a portion of the CFTR gene with the most prevalent CF-causing mutations.
The paper’s other authors are Hung-Che Kuo, Kuang Hu, You-Chiun Chang, Kamyab Javanmardi, Brittney Voigt, Yi-Ru Li, Mary E. Little, Sravan K. Devanathan, Blerta Xhemalçe and Ryan S Gray.
Buffington, J. D., et al. (2025). Discovery and engineering of retrons for precise genome editing. Nature Biotechnology. doi.org/10.1038/s41587-025-02879-3